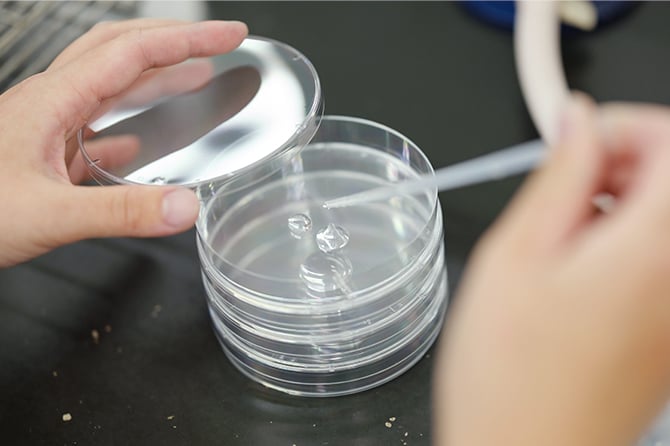

インタビュー
日本ハム食品に入社したきっかけ・決め手は?
学生時代に企業研究を進める中で、自分が楽しみながら頑張れる仕事は「食」に関わる分野であると感じ、食品関連企業に絞って就職活動を行いました。なかでも、自信をもって「おいしい」と周囲に勧められる商品を作っている会社で働きたいと考えました。私は日本ハム食品のピザが大好きなので、全国のお客様へ自身が携わった商品を届けられる点に魅力を感じ、日本ハム食品への入社を決意しました。
現在の仕事内容を教えてください。
製造された商品や原材料の微生物検査、理化学検査が主な業務です。また、工場内の衛生管理指導や、製造部門と協力し品質トラブルを未然に防ぐための改善活動も行っています。日本ハム食品は製造アイテムが多岐にわたるため、製造工程や使用資材も多様であり、さまざまな視点から日々学びを深めています。責任の重い仕事ではありますが、社内の方々と密にコミュニケーションをとりながら業務を進めています。

お客様を笑顔にする商品をお届けするために心がけていること
「1秒」「1個」「1g」にこだわり、製品に妥協せず、常に高い品質を維持するよう努めています。また、様々な部署と連携し、検査結果をフィードバックしたり、品質保証の目線を共有したりすることで改善活動を進めています。日々の検査はルーチンワークである部分も多いですが、何気ない変化も見逃さず、細部にまで気を配ることで、お客様の安心・安全を守り、心からの笑顔をご提供できると考えています。
今後の抱負を教えてください
品質保証のスペシャリストになりたいと考えています。そのためには、法律、規格、検査手法などの、食品衛生や品質管理に関する専門知識を身につける必要があります。日本ハム食品は、e-ラーニングや自己啓発を目的とした通信講座の支援も豊富にあるため、そういった支援を活用して自己成長につなげていきたいと考えています。

私の推し商品
石窯工房® 直火焼きテリヤキチキン


甘みのある味がとても美味しいです。また、製造課員として働いていた頃に自分が担当だった商品でもあるので、愛着があります。

1日の流れ
-
8:00
出社、検査準備
培地作成、機器の滅菌などを行う。
-
9:00
朝礼
お客様からのお問い合わせ内容の共有や、前日の製造トラブルの共有を行う。
-
10:00
サンプリング作業
製造した商品のサンプル回収を行う。
-
11:00
培養作業
各検査内容に合わせて検査を進める。
-
13:00
昼食
昼休憩。社員食堂で食事をとる。
-
14:00
結果確認作業
検査結果の確認、確認試験の実施。
-
15:00
片付け
片付け、翌日の検査準備を行う。
-
16:00
PC業務
メール返信や報告書の作成などを行う。
-
17:30
退社
夜勤担当者への引継ぎ後、退社する。
休日の過ごし方は?
私の趣味は釣り、水族館巡り、音楽、ゲームなど多岐にわたり、休日も充実して過ごしています。会社の同僚と出かけることもあり、同期とテーマパークに遊びに行ったこともあります。また、後輩社員からのお誘いで飲み会に参加することもあり、公私ともに有意義に過ごしています。











